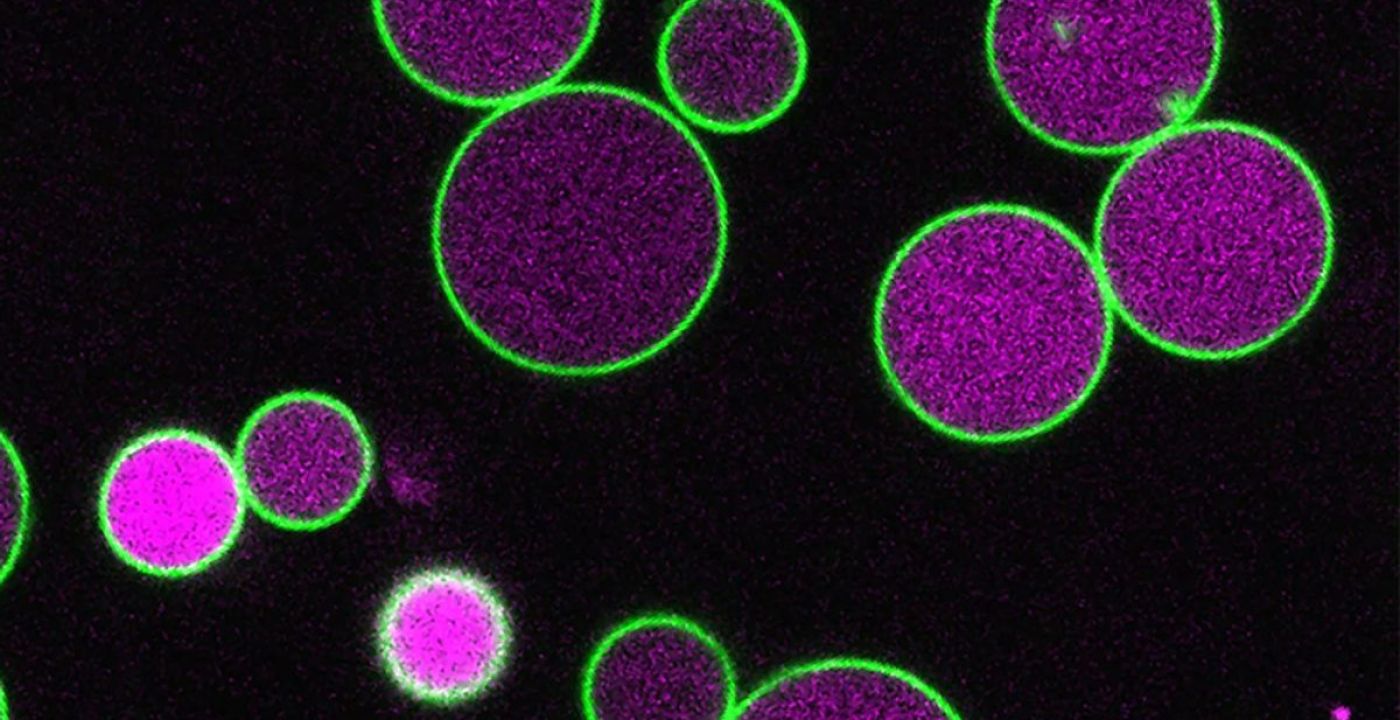

राइस विश्वविद्यालय के शोधकर्ताओं ने पेरोक्सिसोम के आकार को नियंत्रित करने वाले ‘पेक्स11’ प्रोटीन की भूमिका की खोज की है। ‘क्रिसपर’ तकनीक का उपयोग करके ‘पेक्स11’ प्रोटीन से जुड़े पांच जीनों का अध्ययन किया गया। यह शोध मानव कोशिकाओं में पेरोक्सिसोम से जुड़े रोगों को समझने और जैव अभियांत्रिकी में नए आयाम जोड़ने में मददगार साबित होगा। १३ वैशाख, काठमाडौं।
बीज के अंकुरण से पौधे बनने की प्रारंभिक अवस्था में, पौधा सूर्य के प्रकाश से खाना (प्रकाश संश्लेषण) नहीं बना पाता, इसलिए यह पूरी तरह से अपने अंदर संचित वसायुक्त अम्लों पर निर्भर रहता है। इस वसा को ऊर्जा में परिवर्तित करने के लिए पौधे की कोशिका के अंदर ‘पेरोक्सिसोम’ नामक एक विशेष संरचना होती है। राइस विश्वविद्यालय के शोधकर्ताओं के अनुसार, यह संरचना मानव कोशिकाओं में भी पाई जाती है और पौधे की कोशिका बड़ी होने के कारण इसे अध्ययन करना अधिक आसान होता है।
प्राध्यापक बोनी बार्टेल के नेतृत्व में की गई इस रिसर्च में पता चला कि ‘पेक्स11’ (PEX11) नामक एक छोटा प्रोटीन पेरोक्सिसोम के आकार को नियंत्रित करने में महत्वपूर्ण भूमिका निभाता है। ‘नेचर कम्युनिकेशन्स’ में प्रकाशित इस अध्ययन के अनुसार, यह प्रोटीन पेरोक्सिसोम को केवल विभाजित करने में मदद नहीं करता, बल्कि पौधे के प्रारंभिक विकास के दौरान इसके अनावश्यक बढ़ने को भी रोकता है।
शोधकर्ता नैथन थार्प ने ‘क्रिसपर’ (CRISPR) तकनीक का उपयोग कर PEX11 प्रोटीन से जुड़े पांच विभिन्न जीनों का विश्लेषण किया। अध्ययन के दौरान यह पाया गया कि जब ये जीन कार्य नहीं करते, तो पेरोक्सिसोम के अंदर छोटे थैली नहीं बन पाते। सामान्य स्थिति में, ये थैलियां पेरोक्सिसोम की बाहरी झिल्ली के हिस्सों को घेरकर उसके आकार को संतुलित बनाए रखती हैं। मानव और अन्य प्रजातियों के लिए इस शोध का महत्व केवल पौधों तक सीमित नहीं है। वैज्ञानिकों ने जब इसी प्रकार के प्रोटीन को पौधों की उत्परिवर्तित कोशिकाओं में रखा, तो वे कोशिकाएं पुनः सामान्य स्थिति में आ गईं। यह इस बात का सबूत है कि इस प्रोटीन का कार्य प्रणाली लाखों वर्षों से विभिन्न प्रजातियों में सहज रूप से विकसित होती आ रही है।





